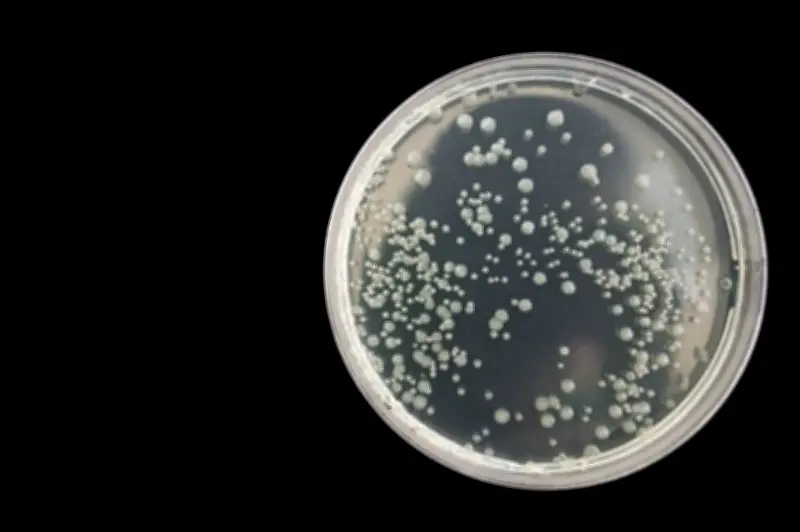
Bacteria de ielo de 5.000 años revela resistencia a antibióticos modernos

Bacteria milenaria en cueva de hielo desafía la medicina moderna
La cueva de hielo de Scărișoara, situada en los montes Apuseni de Rumania, es reconocida como una de las cuevas glaciares más investigadas a nivel global. En su interior, alberga un bloque de hielo perenne de aproximadamente 100.000 metros cúbicos, formado hace unos 13.000 años al final de la última glaciación. Estudios recientes, empleando técnicas moleculares como el análisis de ADN, han desvelado la existencia de una comunidad microbiana rica y compleja atrapada en este hielo, incluyendo bacterias y otros microorganismos congelados durante milenios.
Descubrimiento de una bacteria antigua con propiedades extremas
En una investigación publicada en la revista científica Frontiers, un equipo de científicos logró aislar una bacteria denominada Psychrobacter sp. SC65A.3, atrapada en hielo de alrededor de 5.000 años de antigüedad. Esta cepa, identificada como perteneciente a la especie P. cryohalolentis, es un poliextremófilo, capaz de tolerar múltiples condiciones extremas simultáneamente, como bajas temperaturas de hasta 15 °C y altas concentraciones de sal, incluyendo cloruro de sodio y magnesio. Estas características son consistentes con un microorganismo que ha sobrevivido en un entorno frío, salino y pobre en nutrientes durante miles de años.
Resistencia a antibióticos y actividad metabólica activa
Lo más impactante de este hallazgo es que la bacteria no solo está bien conservada, sino que muestra una amplia actividad hidrolítica, indicando que posee herramientas metabólicas activas. Además, demostró resistencia a 10 antibióticos pertenecientes a 8 clases distintas, incluyendo familias cruciales en la práctica clínica moderna como cefalosporinas de tercera generación, fluoroquinolonas, aminoglucósidos y rifampicina. Estos medicamentos se utilizan actualmente para tratar infecciones respiratorias, urinarias, gastrointestinales y hospitalarias, así como cuadros graves causados por bacterias resistentes.
Según Cristina Purcarea, autora principal del estudio y científica sénior del Instituto de Biología de Bucarest de la Academia Rumana, "los 10 antibióticos a los que encontramos resistencia se emplean ampliamente en terapias orales e inyectables para tratar una variedad de infecciones bacterianas graves". Enfermedades como tuberculosis, colitis e infecciones urinarias pueden tratarse con algunos de estos antibióticos, como rifampicina, vancomicina y ciprofloxacina.
Genes de resistencia y potencial biotecnológico
El análisis del genoma de la bacteria reveló más de 100 genes asociados a resistencia antimicrobiana, incluyendo genes implicados en resistencia clínica importante, bombas de eflujo que expulsan sustancias tóxicas, y genes relacionados con resistencia a metales pesados. Purcarea resumió: "La cepa bacteriana Psychrobacter SC65A.3, a pesar de su origen antiguo, muestra resistencia a múltiples antibióticos modernos y es portadora de más de 100 genes relacionados con la resistencia".
Además, esta bacteria antigua posee la capacidad de inhibir el crecimiento de 14 patógenos del grupo ESKAPE, que incluyen superbacterias como SARM, Enterococcus faecium, Pseudomonas aeruginosa, Klebsiella pneumoniae y Acinetobacter baumannii. En ensayos de laboratorio, produjo compuestos que frenaron o impidieron el crecimiento de estos microorganismos, abriendo tanto riesgos como oportunidades.
Riesgos y oportunidades ante el cambio climático
Purcarea advirtió sobre una paradoja crucial: "Si el derretimiento del hielo libera estos microbios, estos genes podrían propagarse a las bacterias modernas, agravando el desafío global de la resistencia a los antibióticos". Sin embargo, también destacó el potencial positivo: "producen enzimas y compuestos antimicrobianos únicos que podrían inspirar nuevos antibióticos, enzimas industriales y otras innovaciones biotecnológicas".
El genoma de la bacteria contiene casi 600 genes de función desconocida y 11 genes con capacidad potencial para destruir o inhibir el crecimiento de otras bacterias, hongos y virus, sugiriendo mecanismos biológicos aún no descritos por la ciencia. Este hallazgo adquiere especial relevancia en el contexto de la resistencia a los antibióticos, una preocupación creciente que la Organización Mundial de la Salud (OMS) ha calificado como una "pandemia silenciosa".
Implicaciones para la ciencia y la medicina
Como la primera secuencia de genoma completo de hielo de cuevas milenarias, Psychrobacter SC65A.3 ofrece una plataforma valiosa para avanzar en la comprensión de los resistomas antiguos. Purcarea concluyó: "Estas bacterias antiguas son esenciales para la ciencia y la medicina, pero una manipulación cuidadosa y las medidas de seguridad en el laboratorio son esenciales para mitigar el riesgo de propagación descontrolada". Este estudio no solo arroja luz sobre la evolución de la resistencia antimicrobiana, sino que también representa una fuente prometedora para aplicaciones en biotecnología, medicina e industria.









